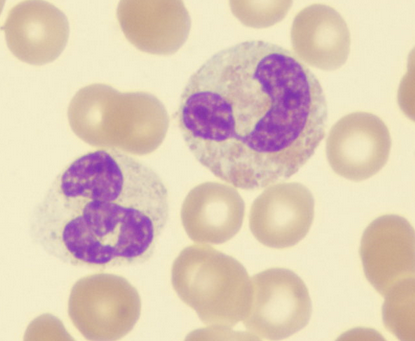
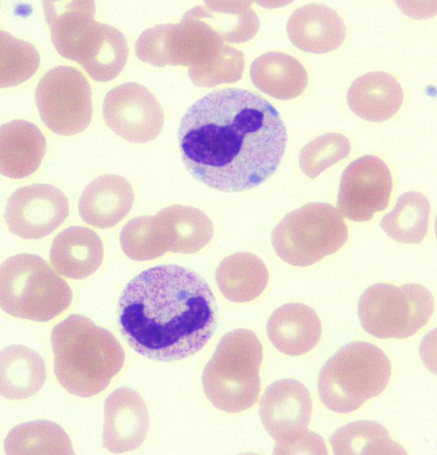
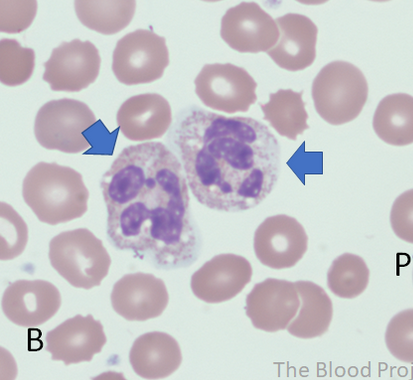
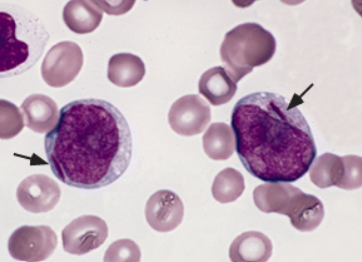
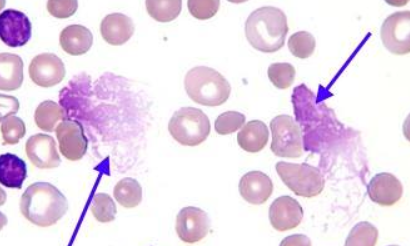
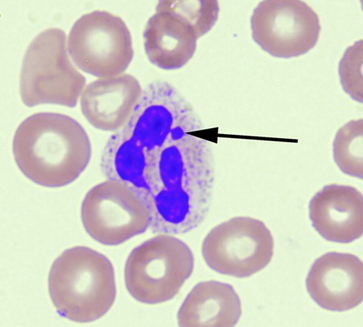
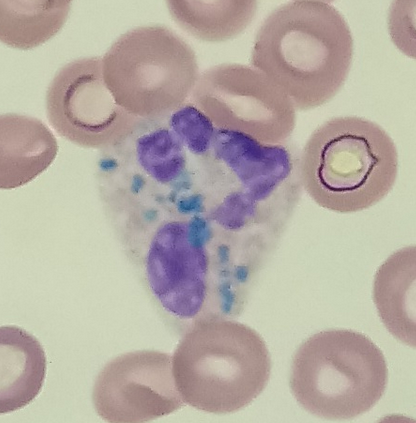

Neutrophil function
Majority of peripheral WBCs
Phagocytosis
Destruction of microorganisms
Contain pyrogen
Eosinophil function
Allgery
Parasitic infection
Inflammation (asthma)
Phagocytosis
Basophil function
Inflammation
Hypersensitivity
Anaphylaxis - IgE receptors, Degranulation, Vasoactive, bronchoconstrictive, chemotatic
Tissue Basophil = mast cell
T cells
Precursors migrate to Thymus and matures here
Helper, suppressor, cytotoxic - different T cell forms
60-80% of peripheral blood lymphs
Markers: Tdt, CD4, CD8
NK cells can kill foreign antigens without antibodies
B cells
Bone marrow
Antibody production
Markers: Surface Ig, CD34, CD19
Monocyte
Phagocytosis
Inhibit bacterial growth
Removes old cells
Antigen processing - involved with innate and adaptive
Scavenger
Primarily a tissue cell

Hypersegmented Neutrophils
5-6 lobes
Response to infection
Hypsegmented Neutrophils
Normal function
Two lobes connected with thin filament
Dohle Bodies
Aggregates of Endoplasmic Reticulum
Toxic change

Toxic Granulation
Associated with infection
Granules stain with dark-blue/black
Vacuoles
Associated with infection, artefact, fat, end stage of microogranism digestion
Auer Rods
Fused Lysosomes
Smudge/Basket Cells
Broken cells
Use Albumin to coat WBC to perform differential
May be artefact
>10/100 WBC

Russell Bodies - Plasma cells
Immunoglobulin
Mott Cell - lots of vacuoles inside
Flame Cell - Associated with IgA
Barr Bodies - no note for differential
“Drumsticks” appearance
Females most notably
Blue-green Crystals
Necrotic hepatocytes in setting of acute liver failure


